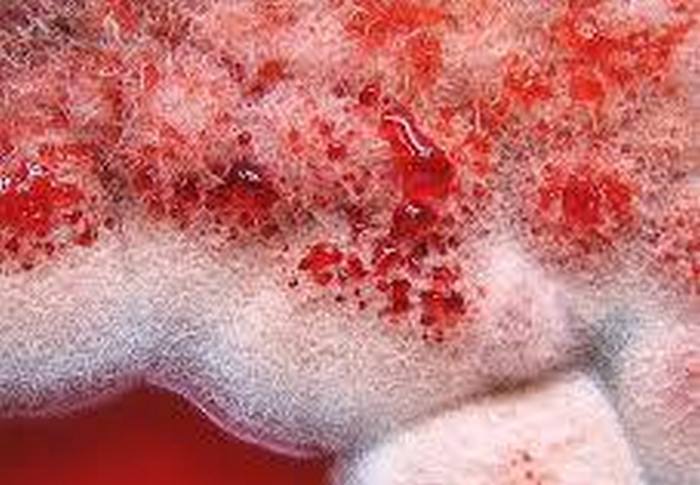

Это цитата сообщения watson71 Оригинальное сообщение
Смертные грехи, в которых мир обвинял евреев...

Так уж повелось, что «народ избранный» - любимый козёл отпущения в мировой истории. Буквально в любой исторический период евреев обвиняли во всё, в чём угодно, - от убийства Иисуса до контроля над миром. Антисемитизм не раз заканчиваться трагически, тем не менее существуют абсурдные обвинения, в которые люди верят.
Гитлер: современное искусство придумали евреи, чтобы сокрушить немецкий дух

По мнению Адольфа Гитлера, современное искусство было не чем иным, как «актом эстетического насилия со стороны евреев против немецкого духа». По-видимому, он вспоминал о своей неудавшейся художественной карьере и решил, что старейшины Сиона стоят за развитием экспериментального искусства. Фюрер даже написал статью, в которой все современное искусство клеймилось, как «дегенеративное» и «еврейское». Он даже выставил некоторые экспонаты современного искусства в Берлине, чтобы показать всем, как это ужасно. Фюрер назвал это выставкой «Дегенеративного искусства».
Но была одна проблема: Гитлер не смог найти достаточное количество еврейских современных (на ту пору) художников, чтобы подтвердить свою теорию. Только 6 из 112 художников, представленных на его выставке, были евреями. Но фюрер не расстроился и объяснил, что другие современные художники, возможно, хоть и не являются сами евреями, но «поддались их влиянию».
Средневековые католики обвиняли евреев в пытках хлеба
В XIII веке католическая церковь заявляла, что евреи являются воплощением зла, поскольку они мучают... хлеб. Они считали, что группа евреев, ненавидевших христиан, крадет гостии (ритуальный евхаристический хлеб), чтобы избивать, мучить и сжигать его. Для католиков это было равносильно пыткам самого Иисуса Христа. Они считали, что гостии фактически превращаются в физическое тело Иисуса, и что евреи ненавидят его так сильно, что чувствуют необходимость снова мучить Иисуса в форме хлеба.
Церковники утверждали, что хлеб кровоточил и вскрикивал от боли, когда евреи мучили его. Современные историки считают, что паника началась из-за того, что как-то священник нашел красный грибок на хлебе, после чего решил, что это кровь.
Генри Форд обвинял евреев в том, что они делают конфеты невкусными

Генри Форд был человеком с многими талантами. Он не только лучше всех в мире продавал автомобили, но и был весьма изобретателен в антисемитских теориях. Форд выпускал газету под названием The Dearborn Independent, которая занималась только тем, что обвиняла евреев во всех смертных грехах.
В газете было опубликовано столько теорий заговора, что даже Адольф Гитлер назвал себя ее фанатом. Но некоторые из теорий заговора были и вовсе сумасбродными на фоне остальных. The Dearborn Independent обвиняла евреев во всем, что только можно себе представить. Если верить газете, то евреи изобрели джаз, и именно они подталкивали общество к самосуду, отравляя их секретным варевом. А ещё, по мнению газеты, евреи саботировали бейсбол только потому, что были слишком ленивыми, чтобы заниматься спортом. А когда Генри Форд как-то попробовал конфету, и ему не понравился ее вкус. Он заявил, что конфету... намеренно испортили евреи.
В средневековой Германии евреев обвинили в Черной смерти

Пандемия чумы, прозванная Черной смертью, уничтожила около 200 миллионов людей в Евразии, а ее разгар происходил в Европе в 1347 - 1351 годах. В то время отчаявшиеся жители решили докопаться до истины относительно того, откуда взялась страшная болезнь. Естественно, во всем обвинили евреев, хотя не было никаких доказательств или оснований полагать, что евреи вызвали самую ужасную вспышку чумы в новейшей истории. Но зачем нужны доказательства, если можно пытать людей, пока они во всем не признаются.
Таким образом, начали жестоко избивать всех подряд евреев, пока один из них, умоляя сохранить ему жизнь, не согласился написать письменное признание, что он наливал яд в колодцы. Другие люди настаивали на том, что чума была не чем иным, как божественным проклятием, поскольку Бог не мог позволить евреям жить. Но различные версии на результат не влияли. Люди по всей Германии, а затем и остальной Европе, начали массово убивать евреев. К примеру, только в одном Франкфурте всего за одну ночь еврейское население сократилось с 19 000 человек до всего лишь 10 человек.
Египетский губернатор обвинил евреев в нападении на людей с помощью дистанционно управляемых акул

Когда в 2010 году акула напала на туристов в Египте, губернатор провинции Южный Синай Мухаммед Абдель Фадиль Шоша был уверен, что он знает, что происходит. Это был не более, чем сионистский заговор с целью дискредитировать туристическую отрасль Египта с помощью киберакул на дистанционном управлении. В качестве возможных вариантов Шоша заявил прессе, что это может быть также «специально обученная сионистская акула» или даже «израильский агент в костюме акулы».
Ваххабиты обвиняют евреев в заговоре с «еврейскими деревьями»

Согласно утверждениям фундаменталистской группы мусульман, называемой ваххабитами, евреи уже начали заговор с тайным союзником: дерезой или, как называют его ваххабиты, «еврейским деревом». В одной из религиозных книг, которые предлагаются обучающимся в Саудовской Аравии, подробно описано, как поступать с евреями: «Судный День не наступит, пока мусульмане не начнут бороться с евреями и убивать их, чтобы евреи начали прятаться за деревьями или камнями. Но и тогда деревья и камни скажут: «О мусульманин, о, раб Божий, за мной спрятался еврей. Приди и убей его». Согласно этой книге, у евреев будет только один союзник во всей природе: дереза. Урок ясен: дело не только в том, что хорошие ваххабиты не могут доверять евреям, но и даже грязным еврейским деревьям.
Палестинская газета обвинила евреев в разведении суперкрыс-убийц

В одной из палестинских газет появилась информация, что Израиль создал породу супер крыс, в два раза больше обычных, исключительно для преследования арабов в Иерусалиме. В статье утверждается, что суперкрысы - кровожадные, обученные убийцы, которые достаточно велики, чтобы убить кошку. Евреи приносят их в город в клетках и выпускают там в арабских кварталах, чтобы те нападали на арабских детей.
Крысы были генетически модифицированы, чтобы размножаться в четыре раза быстрее обычных животных. А самым впечатляющим является то, что суперкрысы были обучены вынюхивать арабскую кровь.
«Нация ислама» и обвинения в рабстве

Согласно утверждению одного из лидеров «Нации Ислама» Акбара Мухаммеда, идея о том, что рабство все еще существует в нашем мире, - это не что иное, как «большая ложь», являющаяся частью «еврейского заговора». Относительно того, что рабство все еще процветает в таких местах, как Судан, Мавритания и Ливия, Акбар заявил, что это всего лишь сионистский заговор и ложь.
Иракская служба безопасности считала покемонов частью сионистского заговора

Возможно, самым великим из всех еврейских заговоров являются покемоны. Согласно отчету службы безопасности Ирака, написанному в 2001 году, самая популярная игра в мире была создана в ходе сионистского заговора о свержении Саддама Хусейна. Иракские службы безопасности утверждали, что «Покемон» является еврейским словом, которое означает «Я еврей». Еврейские заговорщики предположительно создали игру, чтобы проникнуть в умы иракских детей и обратить их против Хусейна. В докладе было предупреждено, что персонаж Покемон уже побывал на иракских рынках и что дети «очень его полюбили».